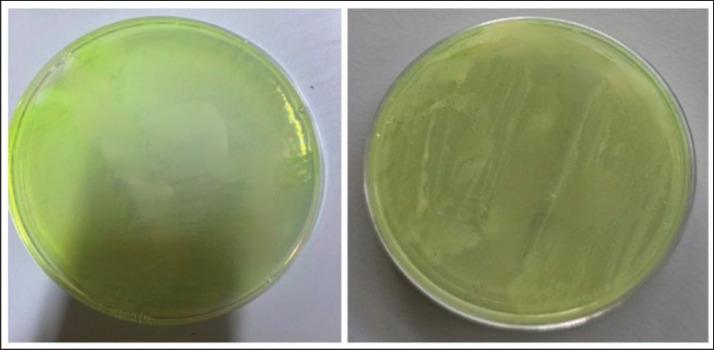

基于临床样本分离株的 基因的多药耐药性和系统发育分析及其对银纳米粒子的敏感性。
Multidrug resistance and phylogenetic analyses of based on the gene of isolates recovered from clinical samples and their susceptibility to silver-nanoparticle.
机构信息
Unit of Zoonotic Disease Research, College of Veterinary Medicine, University of Al-Qadisiyah, Al-Diwaniyah City, Iraq.
Department of Veterinary Microbiology, College of Veterinary Medicine, University of Al-Qadisiyah, Al-Diwaniyah City, Iraq.
出版信息
Open Vet J. 2024 Sep;14(9):2433-2440. doi: 10.5455/OVJ.2024.v14.i9.32. Epub 2024 Sep 30.
BACKGROUND
is a highly antimicrobial-resistant pathogen with a very narrow range of effective antibacterial agents. Therefore, finding alternative compounds is highly required, such as silver nanoparticles (AgNPs).
AIM
The current study was conducted to identify the multidrug resistance (MDR) profile and perform a phylogenetic analysis on isolates recovered from clinical samples (human, cows, cats, and fish) and to study their susceptibility to AgNPs.
METHODS
40 samples were subjected to conventional cultivation and biochemical analyses to identify . Moreover, these isolates were tested for their antibiotic resistance profile and their response to AgNPs using disk diffusion methods. PCR and Sanger-based sequencing were performed using the 16S rRNA gene as a target.
RESULTS
The results showed that all isolates were resistant to cefixime and sensitive to meropenem. Conversely, the AgNPs were effective in producing larger zones of inhibition. The PCR revealed amplification of the target, and the sequencing and phylogenetic tree of four isolates revealed close similarity with global human sequences from different regions.
CONCLUSION
The study reveals the MDR characteristics of . The isolates are highly susceptible to silver nanoparticles.
背景
是一种具有高度抗微生物性的病原体,其有效的抗菌药物范围非常狭窄。因此,非常需要寻找替代化合物,如银纳米粒子(AgNPs)。
目的
本研究旨在鉴定从临床样本(人、牛、猫和鱼)中分离出的 的多药耐药(MDR)谱,并对其进行系统发育分析,同时研究其对 AgNPs 的敏感性。
方法
对 40 个样本进行常规培养和生化分析以鉴定 。此外,还使用圆盘扩散法测试这些分离株的抗生素耐药谱和对 AgNPs 的反应。使用 16S rRNA 基因作为靶标进行 PCR 和基于 Sanger 的测序。
结果
结果表明,所有分离株均对头孢克肟耐药,对美罗培南敏感。相反,AgNPs 有效地产生了更大的抑制区。PCR 显示出目标的扩增,对四个分离株的测序和系统发育树分析显示与来自不同地区的全球人类序列具有密切相似性。
结论
本研究揭示了 的多药耐药特征。分离株对银纳米粒子高度敏感。